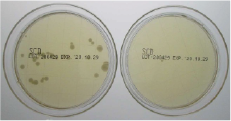

毎日使用することが欠かせない生活の一部になったマスク。
一日中使うからこそ、匂いや衛生面が気になりませんか。
マスクは菌が繁殖しやすく、ウイルスが付着したマスクを使うことは逆効果です。
また、素肌に直接付けるからこそ、マスクから香る自分の匂いに敏感になっていませんか。
朝から晩まで外せないマスクだからこそ、
いつでも使える携帯用マスクスプレーで香り違い2種類をラインナップ。
清潔で爽やかな香りの快適なマスクライフへ。
ラグジュアリー・ライフスタイルホテル「W Osaka」 が、
Herb Garden 除菌マスクスプレーを採用!

世界最大のホテルグループ、マリオット・インターナショナルが展開するトップラグジュアリー・ライフスタイルブランド「W」 が、日本初上陸。大阪心斎橋に「W Osaka 」 をオープン※1します。
斬新かつクリエイティビティ溢れるデザインコンセプトと国内外から集結したホテルスタッフによって、刺激的な空間と時間で満ちる「W Osaka」は、Herb Garden除菌マスクスプレーの内容成分や使用感、デザインを評価し、採用することを決定しました。
「W Osaka」は、常時清潔なマスクを着用したホテルスタッフ※2によって、多くのお客様を温かく、そしてエネルギッシュに迎えることになります。
- ※1 2021年3月16日を予定
- ※2 一部スタッフを除く
ハーブガーデン除菌マスクスプレーは、抗菌や消臭等に
効果のある
植物由来成分を配合し、
マスク内を快適な状態に整えます。
-

- 抗菌
- グレープフルーツ種子エキス
-

- 抗菌・清涼感
- ユーカリグロプルス精油
-

- 抗菌
- ティートゥリー精油
-

- 除菌・消臭
- レモングラス精油
-

- 抗菌・抗酸化
- ローズマリー精油

- 除菌試験の結果、ハーブガーデン除菌マスクスプレーの使用は、
マスクの菌を大幅に除去しており、優れた効果が確認できます。 
- 塩化ベンザルコニウム0.05%以上の配合等により、
除菌効果が長く継続するため、付着する菌を除去します。
微生物の生育結果
-
- スプレーなし
-

-
- スプレーあり
-

サンプル❶
-
サンプル❷ -

サンプル❸
6時間着用済みマスクに対象商品を10回噴射し、
32.5℃で48時間培養
対象商品:ハーブガーデン除菌マスクスプレー
グレープフルーツミント
- *全ての菌に対して効果があるわけではありません。
- *使用環境により、持続力は異なります。
効果は噴霧した部分に限ります。
ハーブガーデン マスクスプレーHerb Garden Mask Spray
塩化ベンザルコニウムをベースにした除菌と、
抗菌に効果が高い植物性天然由来成分5種を配合し、
マスクの除菌と消臭を実現。
ミントとグレープフルーツの香りで、
蒸れたマスクを瞬時に清涼感をもたらし、快適に!
成分 : 精製水、植物由来アルコール(サトウキビ発酵液)、
植物天然由来成分(グレープフルーツ種子エキス、ユーカリ精油、
ティートゥリー精油、レモングラス精油、ローズマリー精油)
塩化ベンザルコニウム、グリチルリチン酸ジカリウム、
グリセリン、ポリソルベート80、PEG-60水添ヒマシ油、香料
マスクスプレーの使い方How to use
マスクの外側に3回プッシュし、
マスクを20秒以上振ってから着用してください。
おしらせ・新着情報
-
- 12/22NEW
- ブランドサイトオープン

















